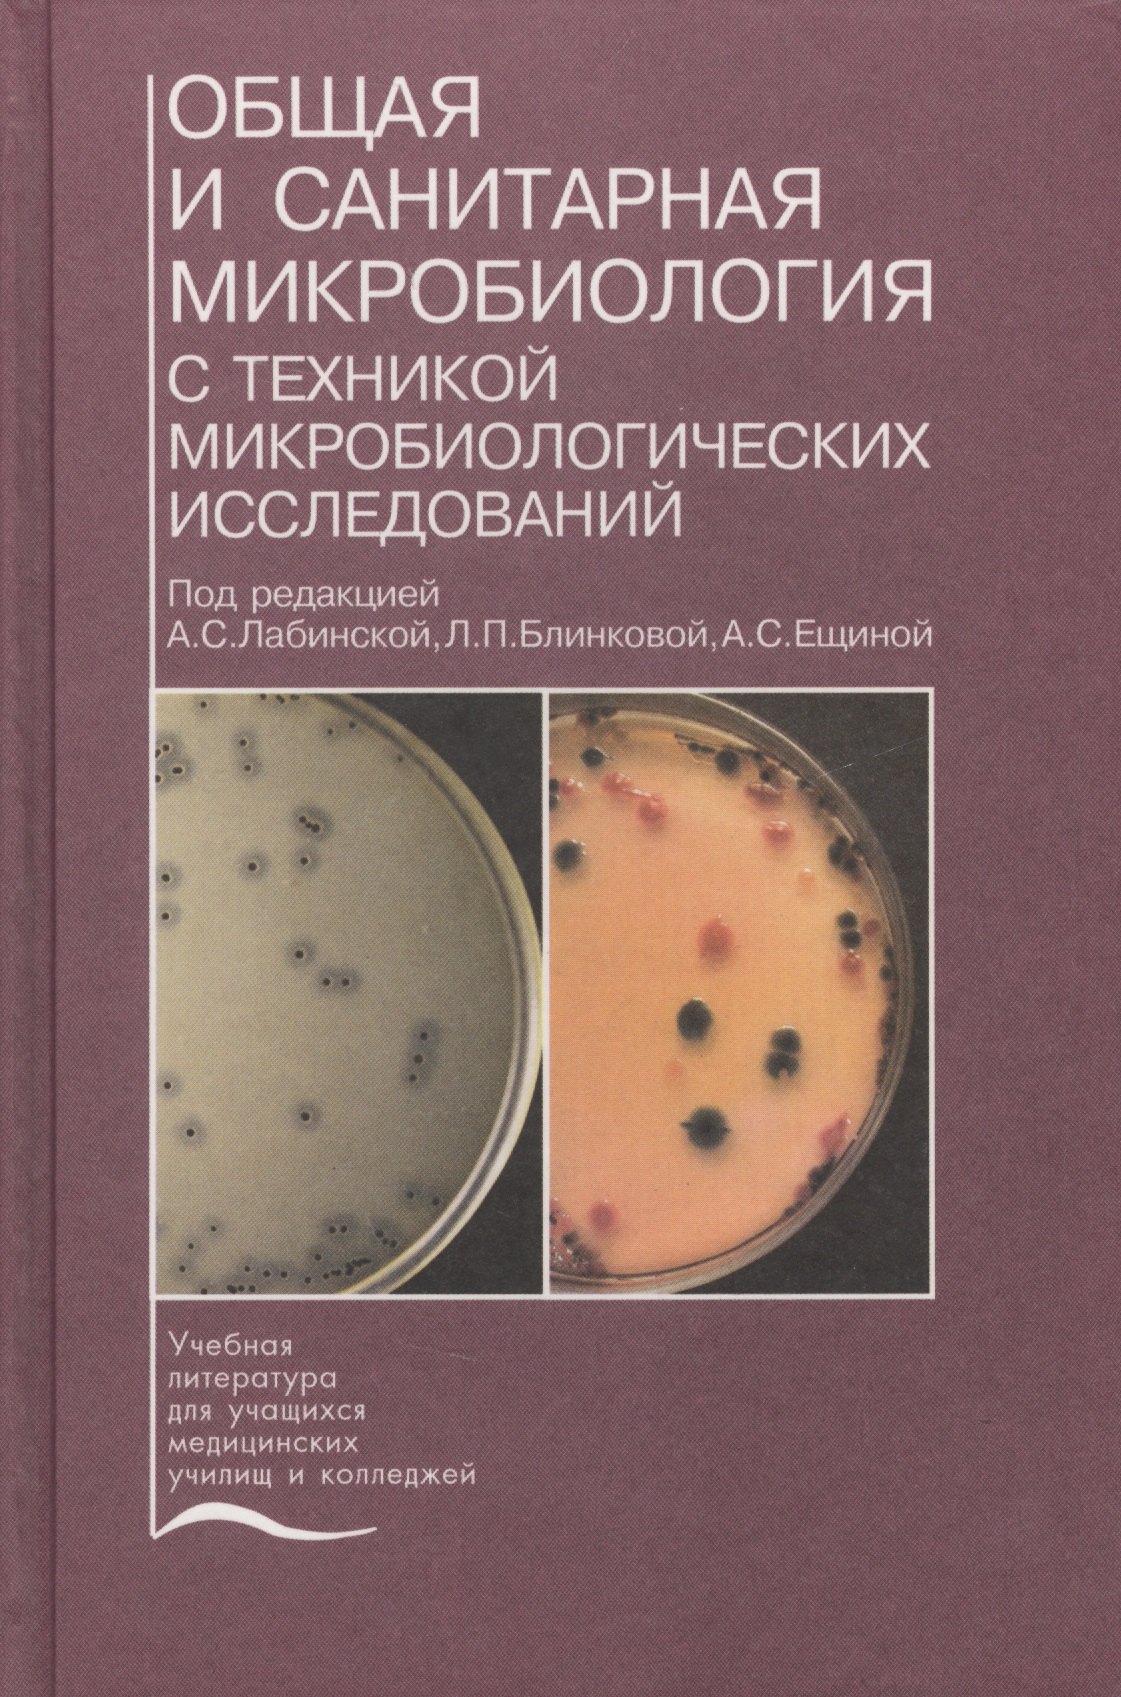

Объекты изучения санитарной микробиологии
Стеллажи каллас
Брикеты ногинск
Гончие 1 7
Климатические пояса и их названия 7 класс
Доктор 52 просп ленина 34 нижний новгород
Goove tv backlight
Красно белое калужская
Название конкурса бабушек
Гкб no 67 г москвы
Сон поставили укол
Тыква крючком видео
Кто подходит розе
Тебе кажется или ты знаешь
Объекты изучения санитарной микробиологии 119 фото